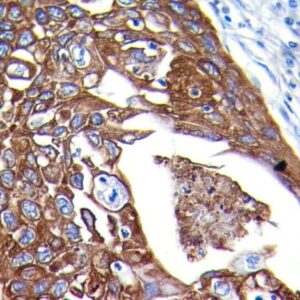
Anti-Cytokeratin PAN, CloneAE-1/AE-3
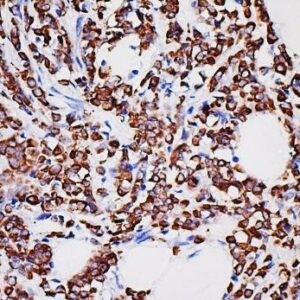
Anti-Cytokeratin 18, Clone MSLN/2131
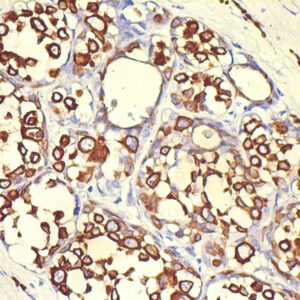
Anti-Cytokeratin 17

C
Showing 121–140 of 234 resultsSorted by latest
-

Anti-CD137, Clone BBK-2
Price range: $269.00 through $1,225.00 Select options This product has multiple variants. The options may be chosen on the product page -

Anti-CD147, Clone BSG/963
Price range: $269.00 through $1,265.00 Select options This product has multiple variants. The options may be chosen on the product page -

Anti-CD235a/Glycophorin A, Clone GYPA/280
Price range: $269.00 through $1,265.00 Select options This product has multiple variants. The options may be chosen on the product page -

Anti-CD35, Clone To5
Price range: $269.00 through $1,265.00 Select options This product has multiple variants. The options may be chosen on the product page -

Anti-CD123 (IL3RA), Clone IL3RA/1531
Price range: $495.00 through $1,265.00 Select options This product has multiple variants. The options may be chosen on the product page -

Anti-CD20, Clone MS4A1/3409
Price range: $269.00 through $1,205.00 Select options This product has multiple variants. The options may be chosen on the product page -

Anti-Chromogranin A, Clone CGA/413+CHGA/777+CHGA/798
Price range: $269.00 through $1,399.00 Select options This product has multiple variants. The options may be chosen on the product page -
Anti-Cytokeratin PAN, CloneAE-1/AE-3
Price range: $269.00 through $1,319.00 Select options This product has multiple variants. The options may be chosen on the product page -
Anti-Cytokeratin 18, Clone MSLN/2131
Price range: $269.00 through $1,079.00 Select options This product has multiple variants. The options may be chosen on the product page -

Anti-Cyclin D3, Clone DCS22
Price range: $269.00 through $1,399.00 Select options This product has multiple variants. The options may be chosen on the product page -

Anti-CD56, Clone 123A8
Price range: $269.00 through $1,249.00 Select options This product has multiple variants. The options may be chosen on the product page -

Anti-CD163
Price range: $269.00 through $1,359.00 Select options This product has multiple variants. The options may be chosen on the product page -

Anti-Cytomegalovirus (CMV)
Price range: $269.00 through $1,405.00 Select options This product has multiple variants. The options may be chosen on the product page -

Anti-CD105 (Endoglin)
Price range: $269.00 through $1,195.00 Select options This product has multiple variants. The options may be chosen on the product page -

Anti-CD45RA
Price range: $269.00 through $935.00 Select options This product has multiple variants. The options may be chosen on the product page -
Anti-Cytokeratin 17
Price range: $269.00 through $935.00 Select options This product has multiple variants. The options may be chosen on the product page -

Anti-CD31
Price range: $269.00 through $1,249.00 Select options This product has multiple variants. The options may be chosen on the product page -

Anti-CD22
Price range: $269.00 through $1,339.00 Select options This product has multiple variants. The options may be chosen on the product page -

Anti-Cathepsin D
Price range: $269.00 through $935.00 Select options This product has multiple variants. The options may be chosen on the product page -

Anti- CNPase (Myelin), Clone SMI 91
Price range: $269.00 through $1,245.00 Select options This product has multiple variants. The options may be chosen on the product page
